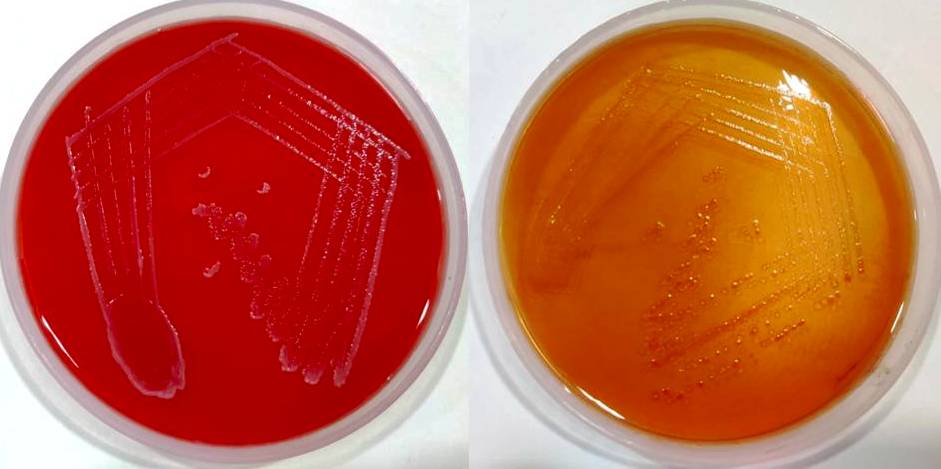

Int J Pharm Pharm Sci, Vol 15, Issue 1, 40-43Case Study
CASE SERIES OF EMERGING NOSOCOMIAL MULTIPLE DRUG RESISTANT PATHOGEN PROVIDENCIA RETTGERI CAUSING URINARY TRACT INFECTION
MAYURI MAHAJAN1, PRASANNA S.2*, NIKUNJA KUMAR DAS3, NIKHIL MAHAJAN4
1Department of Microbiology and Pathology, Dr Hedgewar Hospital and Research Centre, Akola, 2*Department of Microbiology, Shri Sathya Sai Medical College and Research Institute, Sri Balaji Vidyapeeth (Deemed to be University), Chengalpattu, Tamil Nadu 603108, 3Department of Microbiology, D. Y Patil Medical College Hospital and Research center, DY Patil Vidyapeeth, Pimpri, Pune, 4Clinical Consultant and Head, Pediatrics and neonatology, Dr Hedgewar Hospital and Research Centre, Akola
*Email: dr_mayurikulkarni@rediffmail.com
Received: 03 Nov 2022, Revised and Accepted: 30 Nov 2022
ABSTRACT
We report Case Series of Emerging Nosocomial Multiple Drug Resistant Pathogen Providencia rettgeri causing Urinary Tract Infections. The most common cause of catheter-associated urinary tract infections (CAUTI), especially with long-term indwelling urinary catheters in elders, are P. rettgeri and P. stuartii. We are reporting 4 cases of UTI, which are hospital-acquired and CAUTI. These cases are admitted to MICU for treatment purposes and later develop fever spikes after a few days and are evaluated and urine culture showed multi-drug-resistant Providencia rettgeri by VITEK. The empirical therapy was discontinued, managed with fosfomycin, and discharged later with follow-up. The various reports showed P. rettgeriis susceptible for amikacin, gentamicin, tobramycin and ciprofloxacin. In our case series, we isolated multi-drug-resistant strains of P. rettgeri that showed resistance to piperacillin-tazobactam, cefuroxime, ceftriaxone, cefepime, ertapenem, imipenem, meropenem, gentamicin, tobramycin, ciprofloxacin, tigecycline, amikacin, colistin and sensitive only to fosfomycin. The significance of P. rettgeri in association with catheter-related bloodstream infections (CRBSI) and catheter-associated urinary tract infections (CAUTI) was unclear. Hence isolation of Providencia species twice from the clinical samples was considered for association with catheter infections. The proper selection of empirical antimicrobials, antibiotic sensitivity testing, avoiding misuse of antibiotics and implementing proper drug holiday and local antibiotic policy are considered appropriate combination protocol for managing emerging multi-drug-resistant nosocomial Providencia rettgeri strains.
Keywords: Emerging, Nosocomial pathogens, Multi-drug-resistant, Providencia rettgeri
© 2023 The Authors. Published by Innovare Academic Sciences Pvt Ltd. This is an open access article under the CC BY license (https://creativecommons.org/licenses/by/4.0/)
DOI: https://dx.doi.org/10.22159/ijpps.2023v15i1.46740. Journal homepage: https://innovareacademics.in/journals/index.php/ijpps.
INTRODUCTION
Rettgeri in 1909 discovered Providencia rettgeri in chickens from a cholera like epidemic [1]. Providencia stuartii, P. rettgeri, P. alcalifaciens, P. rustigianii, and P. heimbachae are urease-producing gram-negative bacillus belong to the Providencia genera under the Enterobacteriaceae family. P. rettgeri and P. stuartii are opportunistic pathogens in residents and hospitalized patients, commonly found in soil, water, and animal reservoirs. The most common cause of catheter-associated urinary tract infections (CAUTI), especially with long-term indwelling urinary catheters in elders, are P. rettgeri and P. stuartii. Usually, the mortality rate will be high among the elderly population when Providencia genera are associated with urinary tract infections (UTI) or bacteraemia. Providencia rettgeriis most commonly associated with long-term indwelling urinary catheters and multi-drug-resistant isolates [2-4].
The essential virulence factors for Proteus species, Morganella species and Providencia species are bacterial urease; type III fimbriae play a pivotal role in the formation of urinary tract stones, obstruction of long-term urinary catheters and complicating acute pyelonephritis [5, 6]. Even though the purple urine bag syndrome is a rare and asymptomatic condition if present, physicians should consider indoxyl sulphatase or phosphatase producing P. stuartii or P. rettgeri [7]. This case series is reported to highlight the importance of this emerging nosocomial pathogen Providencia rettgeri and to understand in depth about prevention and management because of multi-drug resistance.
Case descriptions
Case 1
A 46-year-old male presented to the emergency department with chest pain, breathlessness on walking, and drowsiness since morning. The patient was a known hypertensive and not a known diabetic. On clinical examination and further investigation, the patient was diagnosed with ischemic heart disease, Post MI pericarditis, type 2 diabetes mellitus, and thrombolysed with retiplase, and the ejection fraction was 42%. He was admitted to the Intensive care unit (ICU), and other routine investigations were done. The nasopharyngeal swab was sent for RT-PCR, and turned out to be COVID-19 negative. All blood investigations were within normal range except blood glucose, and cholesterol and the patient was catheterized by Foley’s catheter. The patient was given insulin and empirical antibiotics because of fever spikes after three days. The blood and urine sample was sent for culture and sensitivity; a Gram stain of urine showed numerous pus cells with gram-negative bacilli. Initially, the patient was managed with a piperacillin and tazobactum combination and completes monitoring.
Case 2
A 78-year-old male presented to the general medicine department with hypoglycaemia and sudden drowsiness for 1 w. The patient was a known hypertensive and diabetic and had no history of stroke or ischemic heart disease. On clinical examination and further investigation, the patient was diagnosed as right side hemi paresis with type 2 diabetes mellitus. He was admitted to ICU, other routine investigations were done, and the patient was catheterised. The nasopharyngeal swab was sent for RT-PCR, and turned out to be COVID-19 negative. All blood investigations were within normal range except for increased WBC count, blood glucose and serum electrolytes. The patient was given insulin and empirical antibiotics because of fever spikes with chills and rigor after a few days. The blood and urine sample was sent for culture and sensitivity; Gram stain of urine showed numerous pus cells with gram-negative bacilli. Initially, a patient was managed with a ceftazidime sulbactam combination and completed monitoring.
Case 3 and 4
There were two cases of chronic liver disease with a known history of diabetes and hypertension admitted to the Medical ICU. All other routine investigations were done, including liver function test. The nasopharyngeal swab was sent for RT-PCR, and turned out to be COVID-19 negative. All blood investigations were within normal range except for increased WBC count, blood glucose, and abnormal liver function tests and the patient was catheterized. The patient was given insulin and empirical antibiotics because of fever spikes after a few days of hospitalization.
The management of all cases
The blood and catheter urine was cultured in blood, chocolate, MacConkey and Sabouraud dextrose agar with aseptic precautions. The urine culture was processed in VITEK and identified as multi-drug-resistant Providencia rettgeri sensitive only to fosfomycin (fig. 1 and fig. 2). All urine culture growth was re-isolated and correlated clinically also. The blood culture was shown no growth. Fosfomycin 3 grams (1 sachet) orally once as a single dose was given along with supplements because all other antimicrobials turned out as resistant (multi-drug resistant Providencia rettgeri) by VITEK. The patient’s vital parameters were stable and discharged later. Further follow-up was ensured about the completion of treatment and improvement based on clinical findings and negative culture reports.
Fig. 1: Colonies of Providencia rettgeri in blood agar (Left side)-non hemolytic semi-translucent colonies; Mac conkey agar (right side)-non-lactose fermenting semi-translucent colonies

Fig. 2: Identification of Providencia rettgeri with antibiotic sensitivity testing by vitek-2 showing multiple drug resistance and sensitive to fosfomycin
DISCUSSION
Providencia genera frequently causes a wound, respiratory and urinary tract infection by Providencia stuartii, P. rettgeri, P. alcalifaciens; gastrointestinal infection and diarrhea by P. alcalifaciens; bloodstream and poultry infection by P. rettgeri, P. heimbachae [1].
The significance and importance of P. rettgeri were first realized in south East Asian countries after the isolation of the same from surgical site infections as clusters in Nepal in 2014 [8]. P. rettgeri have been isolated as an etiological agent in 1986 (gastrointestinal illness), 2004 (traveler’s diarrhea) and 20067 (ocular infection) [9-11]. In our case series, we isolated P. rettgeri from catheter urine samples causing CAUTI.
The clinical isolates showed resistance to antibiotics like amikacin (86%) and gentamicin (71%), as reported in a study carried out by Wie SH [12]. The extended spectrum beta-lactamase (ESBL) and New Delhi Metallo-beta lactamases-1 (NDM-1) producing strains of Providencia rettgeri have been reported in New Delhi, Eastern Europe, South America and Asia. The carbapenemase enzyme produced by NDM-1 strains of Providencia species is responsible for carbapenems resistance among P. rettgeri [13-15].
P. rettgeri and P. stuartii produce resistance to tobramycin and gentamicin commonly. However, both are susceptible or intermediate to gentamicin also. P. rettgeri showed earlier sensitivity to antibiotics like ciprofloxacin, cephalosporin, carbapenems and amoxicillin-clavulanate. However, emerging resistance to ciprofloxacin has been reported among Providencia species with a shift in sensitivity pattern from 100% to 46% in a study carried out by Fass RJ et al. [16-18]. In our case series, we isolated multi-drug-resistant strains of P. rettgeri showed resistance to piperacillin-tazobactam, cefuroxime, ceftriaxone, cefepime, ertapenem, imipenem, meropenem, gentamicin, tobramycin, ciprofloxacin, tigecycline, amikacin, colistin and sensitive only to fosfomycin. P. rettgeri is known to be resistant to gentamicin and tobramycin but susceptible to Amikacin. All these findings together alarm us to follow routine antibiotic sensitivity testing for Providencia species.
The significance of Providencia rettgeri in association with catheter-related bloodstream infections (CRBSI) and catheter-associated urinary tract infections (CAUTI) was not clear. Hence isolation of Providencia species twice from the clinical samples was considered for association with catheter infections. This association of CRBSI and CAUTI in Providencia species was reported by Wang TK et al. linking with bacterial urease production and biofilm formation among indwelling catheters used in peritonitis cases. The biofilm formation is responsible for inactive antimicrobial response in Providencia rettgeri by affecting penetration of and reducing the bioavailability in vivo [19, 20]. In our case series, we isolated multi-drug-resistant strains of P. rettgeri from catheterized patients.
The proper selection of empirical antimicrobials, antibiotic sensitivity testing, avoiding misuse of antibiotics and implementing proper drug holidays and local antibiotic policy are considered appropriate combination protocols for managing emerging multi-drug-resistant nosocomial Providencia rettgeri strains. In our case, we fumigated the ICU after swabbing of the various sites in ICUs and cultured Providencia rettgeri and coagulase-negative Staphylococcus. Henceforth proper hand hygiene practices were strictly enrolled as per guidelines in wards and ICUs by the Hospital Infection Control Committee.
CONCLUSION
The differential diagnosis of Providencia species like P. rettgeri and P. stuartii among Enterobacteriaceae should be in our mind in the case of elderly with long-term indwelling catheters and empirical treatment failure. All clinical samples like urine, blood, sputum, pleural fluids, and BAL must also be screened for Providencia species in suspected presentations. The early diagnosis and management of UTI, CAUTI and other infections with specific antimicrobial therapy decides the patient’s prognosis. As such, in association with obstruction, strictures and calculi, we must consider Providencia, Morganella and Proteus species as differential diagnoses and manage keenly with a combination of antimicrobials to save the patient at the earliest.
ACKNOWLEDGMENT
Nil
FUNDING
Nil
AUTORS CONTRIBUTIONS
First author contributions: Lab diagnosis and reporting
Second and corresponding author contributions: Lab Diagnosis, complete write-up, photos and editing.
Third author Contributions: Editing and compilation
Fourth author contributions: Supportive clinical diagnosis
CONFLICT OF INTERESTS
Declared none
REFERENCES
O’Hara CM, Brenner FW, Miller JM. Classification, identification, and clinical significance of Proteus, Providencia, and Morganella. Clin Microbiol Rev. 2000;13(4):534-46. doi: 10.1128/CMR.13.4.534, PMID 11023955.
Armbruster CE, Smith SN, Yep A, Mobley HL. Increased incidence of urolithiasis and bacteremia during proteus mirabilis and providencia stuartii coinfection due to synergistic induction of urease activity. J Infect Dis. 2014;209(10):1524-32. doi: 10.1093/infdis/jit663, PMID 24280366.
Hawkey PM. Providencia stuartii: a review of a multiply antibiotic-resistant bacterium. J Antimicrob Chemother. 1984;13(3):209-26. doi: 10.1093/jac/13.3.209, PMID 6373713.
Warren JW. Providencia stuartii: a common cause of antibiotic-resistant bacteriuria in patients with long-term indwelling catheters. Rev Infect Dis. 1986;8(1):61-7. doi: 10.1093/clinids/8.1.61, PMID 3081988.
Jones BD, Mobley HL. Genetic and biochemical diversity of ureases of proteus, Providencia, and Morganella species isolated from urinary tract infection. Infect Immun. 1987;55(9):2198-203. doi: 10.1128/iai.55.9.2198-2203.1987, PMID 3623698.
Darouiche RO. Device-associated infections: a macroproblem that starts with microadherence. Clin Infect Dis. 2001;33(9):1567-72. doi: 10.1086/323130, PMID 11577378.
Al-Jubouri MA, Vardhan MS. A case of purple urine bag syndrome associated with Providencia rettgeri. J Clin Pathol. 2001;54(5):412. doi: 10.1136/jcp.54.5.412-a, PMID 11328846.
Tada T, Miyoshi Akiyama T, Dahal RK, Sah MK, Ohara H, Shimada K. NDM-1 Metallo-β-lactamase and ArmA 16S rRNA methylase producing providencia rettgeri clinical isolates in Nepal. BMC Infect Dis. 2014;14:56. doi: 10.1186/1471-2334-14-56, PMID 24484534.
Müller HE. Occurrence and pathogenic role of organelle-proteus-Providencia group bacteria in human feces. J Clin Microbiol. 1986;23(2):404-5. doi: 10.1128/jcm.23.2.404-405.1986, PMID 3517057.
Yoh M, Matsuyama J, Ohnishi M, Takagi K, Miyagi H, Mori K. Importance of Providencia species as a major cause of travellers’ diarrhoea. J Med Microbiol. 2005;54(11):1077-82. doi: 10.1099/jmm.0.45846-0, PMID 16192440.
Koreishi AF, Schechter BA, Karp CL. Ocular infections caused by Providencia rettgeri. Ophthalmology. 2006;113(8):1463-66. doi: 10.1016/j.ophtha.2006.03.047, PMID 16797710.
Wie SH. Clinical significance of Providencia bacteremia or bacteriuria. Korean J Intern Med. 2015;30(2):167-9. doi: 10.3904/kjim.2015.30.2.167, PMID 25750557.
Marchandin H, Carriere C, Sirot D, Pierre HJ, Darbas H. TEM-24 produced by four different species of Enterobacteriaceae, including providencia rettgeri, in a single patient. Antimicrob Agents Chemother. 1999;43(8):2069-73. doi: 10.1128/AAC.43.8.2069, PMID 10428940.
Cornaglia G, Frugoni S, Mazzariol A, Piacentini E, Berlusconi A, Fontana R. Activities of oral antibiotics on providencia strains isolated from institutionalized elderly patients with urinary tract infections. Antimicrob Agents Chemother. 1995;39(12):2819-21. doi: 10.1128/AAC.39.12.2819, PMID 8593030.
Barrios H, Garza Ramos U, Reyna Flores F, Sanchez Perez A, Rojas Moreno T, Garza Gonzalez E. Isolation of carbapenem-resistant NDM-1-positive providencia rettgeri in mexico. J Antimicrob Chemother. 2013;68(8):1934-6. doi: 10.1093/jac/dkt124. PMID 23620464.
Usharani P. Incidence and outcome of multidrug-resistant aerobic gram-negative bacteria causing various clinical infections. Asian J Pharm Clin Res. 2021. Dec 15;2:123-6. doi: 10.22159/ajpcr.2022.v15i2.43436.
Mehta A, Kr Diwakar M. Characterization and antimicrobial susceptibility profile of non-lactose fermenting gram-negative bacterial isolates in a tertiary care teaching hospital of central India. Asian J Pharm Clin Res. 2021. Oct;14(10):41-7. doi: 10.22159/ajpcr.2021.v14i10.42822.
Fass RJ, Barnishan J, Ayers LW. Emergence of bacterial resistance to imipenem and ciprofloxacin in a university hospital. J Antimicrob Chemother. 1995;36(2):343-53. doi: 10.1093/jac/36.2.343, PMID 8522464.
Blaser MJ, Dolin R, Mandell GL, Douglas RG1, Bennett JE, Mandell, Douglas, and Bennett’s principles and practice of infectious diseases. 8th ed. Philadelphia: Elsevier/Saunders; 2015.
Wang TK, Ahn Y, Dunlop J. Providencia rettgeri peritonitis in a patient on peritoneal dialysis with perforated appendicitis. Perit Dial Int. 2014;34(5):569-70. doi: 10.1177/089686081403400501, PMID 25075004.